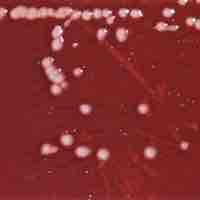
Thumbnail

Chapter 5
Microbial Metabolism
By Boundless

Photoautotrophs and photoheterotrophs are organisms that rely on light as their source of energy to carry out cellular processes.

Chemoautotrophs and chemoheterotrophs make their food using chemical energy rather than solar energy.

Catabolic pathways are controlled by enzymes, proteins, electron carriers, and pumps that ensure that the remaining reactions can proceed.

Cellular respiration is the process of transforming chemical energy into forms usable by the cell or organism.
Sugars, such as galactose, fructose, and glycogen, are catabolized into new products in order to enter the glycolytic pathway.

Glycolysis is the first step in the breakdown of glucose to extract energy for cellular metabolism.

Electrons can enter the electron transport chain at three levels: dehydrogenase, the quinone pool, or a mobile cytochromeelectron carrier.

The amount of energy (as ATP) gained from glucose catabolism varies across species and depends on other related cellular processes.

Respiration is one of the key ways a cell gains useful energy to fuel cellular activity.

A cofactor is a non-protein chemical compound that is bound to a protein and is required for the protein's biological activity.

In biochemistry, an oxidoreductase is an enzyme that catalyzes the transfer of electrons from one molecule to another.

ATP synthase is an important enzyme that provides energy for the cell to use through the synthesis of adenosine triphosphate.

Most bacteria rely on proton motive force as a source of energy for a variety of cellular processes.

The citric acid cycle is a series of reactions that produces two carbon dioxide molecules, one GTP/ATP, and reduced forms of NADH and FADH2.

After glycolysis, pyruvate is converted into acetyl CoA in order to enter the citric acid cycle.

The citric acid cycle is a key component of the metabolic pathway by which all aerobic organisms generate energy.

The Entner–Doudoroff pathway is an alternate series of reactions that catabolize glucose to pyruvate.
Microbes can utilize hydrocarbons via oxidation as an energy source.

The pentose phosphate pathway (PPP) converts glucose-6-phosphate into NADPH and pentoses (5-carbon sugars).

Microbes can harness energy and carbon derived from organic acids by using a variety of dedicated metabolic enzymes.

Biological lipids, which are broken down and utilized though β-oxidation, represent a potent energy source.

Excess amino acids are converted into molecules that can enter the pathways of glucose catabolism.

Methylotrophs and methanotrophs are a diverse group of microorganisms that can derive energy from the metabolism of single-carbon compounds.

Some prokaryotes and eukaryotes use anaerobic respiration in which they can create energy for use in the absence of oxygen.

Acetogenesis is a biological reaction wherein volatile fatty acids are converted into acetic acid, carbon dioxide, and hydrogen.

Fermentation is the process of extracting energy from the oxidation of organic compounds such as carbohydrates.

Syntrophy is the phenomenon where one species lives off the products of another species.

In anaerobic respiration, a molecule other than oxygen is used as the terminal electron acceptor in the electron transport chain.

Denitrification is a type of anaerobic respiration that uses nitrate as an electron acceptor.

Sulfate reduction is a type of anaerobic respiration that utilizes sulfate as a terminal electron acceptor in the electron transport chain.

Methanogenesis is a form of anaerobic respiration that uses carbon as a electron acceptor and results in the production of methane.

Anaerobic respiration utilizes highly reduced species - such as a proton gradient - to establish electrochemical membrane gradients.

Anoxic hydrocarbon oxidation can be used to degrade toxic hydrocarbons, such as crude oil, in anaerobic environments.

Chemolithotrophs use electron donors oxidized in the cell, and channel electrons into respiratory chains, producing ATP.

While there are several mechanisms of anaerobic hydrogen oxidation, organisms can also use hydrogen as an energy source aerobically.

Sulfur oxidation involves the oxidation of reduced sulfur compounds, inorganic sulfur, and thiosulfate to form sulfuric acid.

Ferric iron is an anaerobic terminal electron acceptor, with the final enzyme a ferric iron reductase.

Nitrification is the process by which ammonia (NH3) or ammonium (NH4+) is converted to nitrite (NO2-) and then nitrate (NO3−) by bacteria.

Anammox, an abbreviation for ANaerobic AMMonium OXidation, is a globally significant microbial process of the nitrogen cycle.

Rhodobacter sphaeroides is able to produce hydrogen from a wide range of organic compounds (chiefly organic acids) and light.

Polycyclic aromatic hydrocarbons are potent atmospheric pollutants that consist of fused aromatic rings and do not contain heteroatoms.

The process of photosynthesis converts light energy to chemical energy, which can be used by organisms for different metabolic processes.

In multicellular autotrophs, the main cellular structures that allow photosynthesis to take place include chloroplasts, thylakoids, and chlorophyll.

Light-dependent and light-independent reactions are two successive reactions that occur during photosynthesis.

Bacteriorhodopsin acts a proton pump, generating cellular energy in a manner independent of chlorophyll.
To aid chlorophylls in the absorption of light not many photosynthetic organisms use carotenoids and phycobilins.

A facultative phototroph can rely on photosynthesis and alternative energy sources to survive and grow.

Oxygenic photosynthesis, provides energy to organism and allows for carbon fixation, all the while producing oxygen as a byproduct.

Photosynthetic reactions can be anoxygenic, thus they do not produce oxygen.

Major metabolic pathways require substrates to be acted upon for the formation of larger, more complex products.

Biosynthetic processes ensure the production of complex products necessary for cellular and metabolic processes.

The Calvin cycle is organized into three basic stages: fixation, reduction, and regeneration.

The Calvin Cycle involves the process of carbon fixation to produce organic compounds necessary for metabolic processes.

The Calvin cycle is a process that ensures carbon dioxide fixation in plants.

The reverse TCA cycle utilizes carbon dioxide and water to form carbon compounds.

The acetyl-CoA pathway utilizes carbon dioxide as a carbon source and often times, hydrogen as an electron donor to produce acetyl-CoA.

The 3-hydroxypropionate cycle is a carbon fixation pathway that results in the production of acetyl-CoA and glyoxylate.

Polysaccharides are synthesized from two forms of activated glucose molecules: UDP-glucose and ADP-glucose.

Many of the immune activating abilities of lipopolysaccharide can be attributed to the lipid A unit.

Attenuation is a regulatory feature found throughout Archaea and Bacteria domains which causes premature termination of transcription.

Polyhydroxyalkanoates or PHAs are linear polyesters produced in nature by bacterial fermentation of sugar or lipids.

Polyketides are secondary metabolites produced from bacteria, fungi, plants, and animals.

Organisms vary in their ability to synthesize the 20 common amino acids, but most bacteria and plants can synthesize all 20.

Unlike pyrimidines, purines are biologically synthesized as nucleotides and in particular as ribotides.

Nonribosomal peptides (NRP) are a class of peptide secondary metabolites which can function as antibiotics.

Porphyrins are the conjugate acids of ligands that bind metals to form complexes.

The process of nitrogen fixation is carried out in microbes.

Nitrogen fixation carried out by bacteria helps farmers yield healthy crops.

The conversion of N2 to NH3 depends on a complex reaction, essential to which are enzymes known as nitrogenases.

Nitrogen fixing bacteria have different strategies to reduce oxygen levels, which interfere with nitrogenase function.

Through control of gene expression, nitrogen fixing bacteria can turn on and off the proteins needed for nitrogen fixation.

